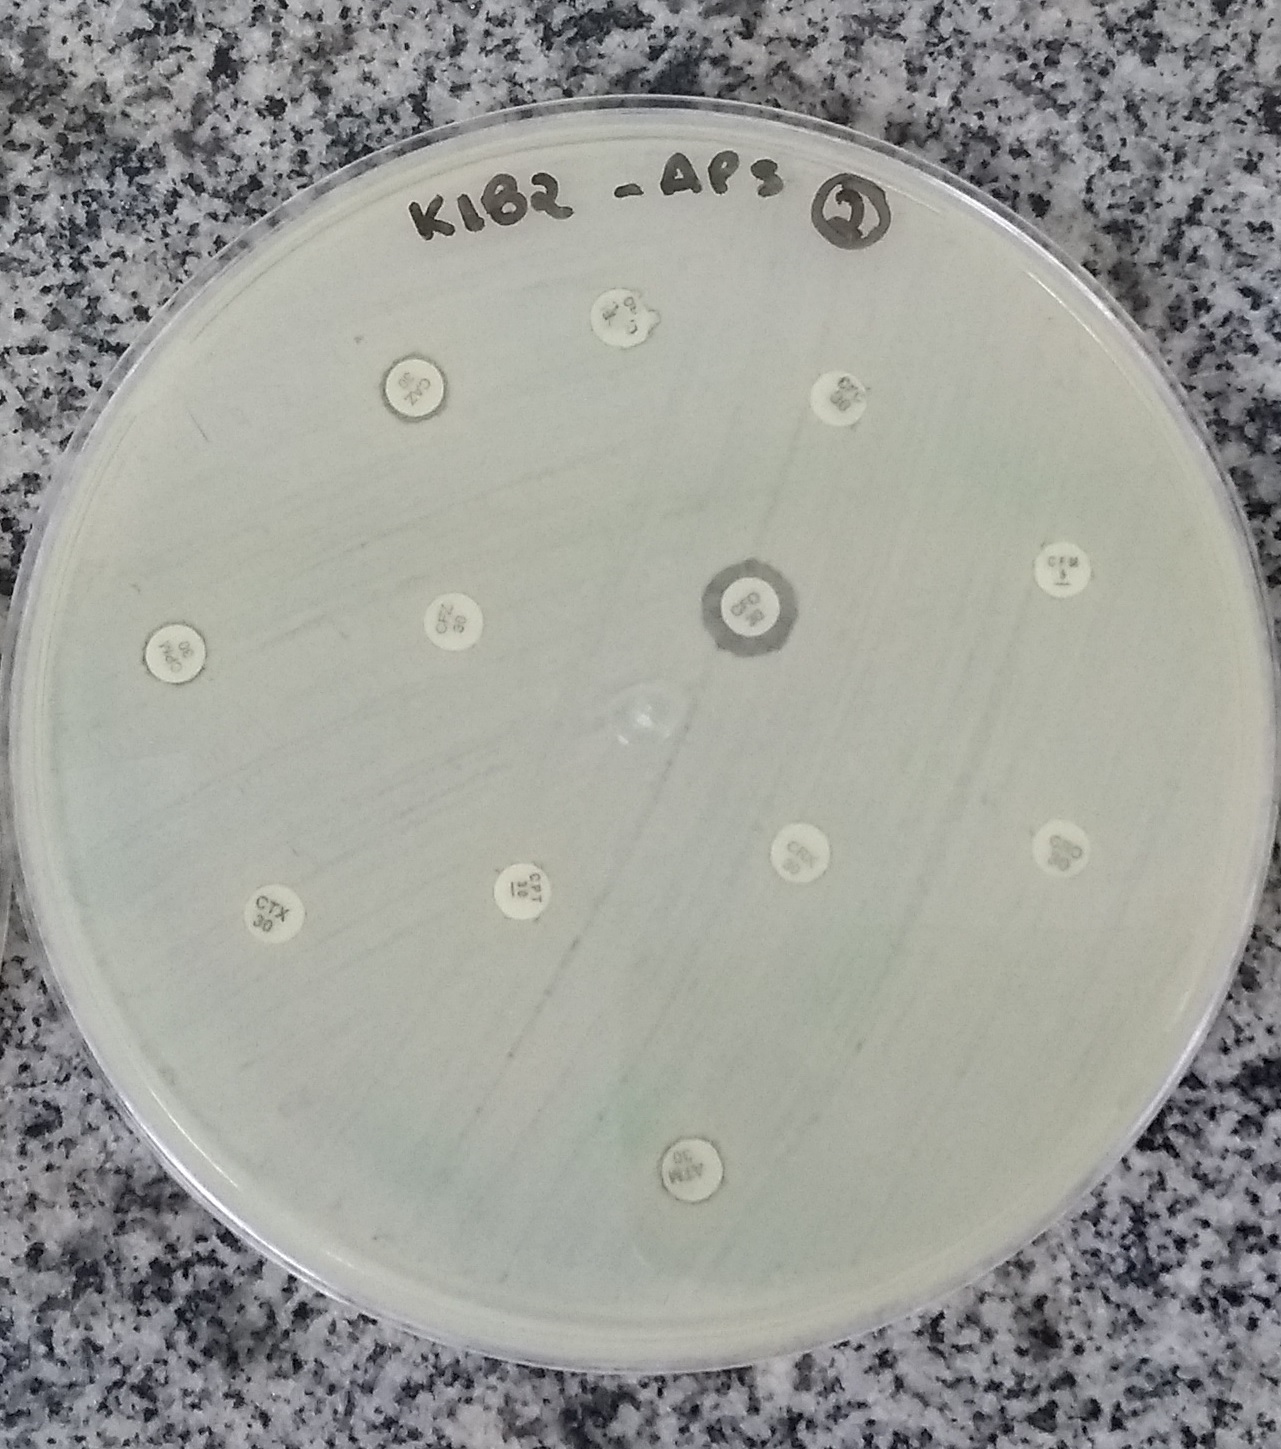

Parte de um grande projeto de pesquisa sobre bactérias de origem hospitalar, o estudo “Draft genome sequences of PDR and XDR Klebsiella pneumoniae belonging to high-risk CG258 isolated from a Brazilian tertiary hospital” (Sequências genômicas de Klebsiella pneumoniae PDR e XDR pertencentes ao CG258 de alto risco, isoladas de um hospital terciário brasileiro), coordenado pelo pesquisador e professor da Unaerp, André Pitondo da Silva, foi publicado na Infection, Genetics and Evolution. A revista cientifica possui grande prestígio internacional, com importantes publicações sobre infecções, genética e evolução de bactérias.
A pesquisa teve o objetivo de estudar apenas bactérias isoladas de pacientes internados em hospitais, mais especificamente, a espécie bacteriana denominada Klebsiella pneumoniae, uma das maiores preocupações nas instituições de saúde do Brasil e do mundo. Considerada um dos mais importantes patógenos oportunistas causadores de infecções hospitalares, especialmente em indivíduos imunocomprometidos, as infecções causadas pela bactéria podem levar a uma série de complicações clínicas, incluindo infecções do trato urinário, pneumonia, septicemia e, em muitos casos, à morte dos pacientes.
Algumas K. pneumoniae podem produzir enzimas chamadas carbapenemases, capazes de inativar vários tipos de antibióticos. As bactérias resistentes a vários antibióticos são popularmente conhecidas como superbactérias, sendo amplamente descritas em hospitais do mundo todo. “No entanto, ainda pouco conhecidas e mais temíveis são as bactérias resistentes a praticamente todos os antibióticos disponíveis para combatê-las, denominadas extensively drug-resistant (XDR) e outras que são resistentes a todos os antibióticos, denominadas pandrug-resistant (PDR)”, explica Pitondo.
No artigo, os pesquisadores descreveram o genoma de duas K. pneumoniae, isoladas de pacientes internados em um hospital terciário, localizado no sul do Brasil. Isolada do sangue do paciente, a bactéria XDR foi sensível a apenas um dos 42 antibióticos testados. Já a PDR, isolada de infecção urinária, foi resistente a todos os 42 antibióticos testados, incluindo a colistina, considerada a última opção terapêutica. “Um outro agravante é que essas bactérias também pertencem ao grupo clonal 258 (CG258), que é um grupo de bactérias que são consideradas de alto risco porque, frequentemente, têm uma grande capacidade de se disseminar no ambiente hospitalar”, complementa o pesquisador.
A partir do sequenciamento dos genomas, foi possível detectar vários genes de resistência aos antimicrobianos, além da presença de genes de virulência, que ajudam as bactérias a sobreviver e infectar o hospedeiro. “Isso significa que, além das opções terapêuticas praticamente inexistentes, as bactérias têm um potencial para causar infecções mais graves nos pacientes”.
Além do apoio da Fundação de Amparo à Pesquisa do Estado de São Paulo – FAPESP, o estudo foi desenvolvido em parceria com pesquisadores do Instituto de Ciências Biomédicas, da Universidade de São Paulo (ICB–SP) e da Universidade de Monah, na Austrália.
O artigo pode ser acessado em: https://authors.elsevier.com/a/1c9HB5aKq2HuTd
Pesquisa teve o objetivo de estudar apenas bactérias isoladas de pacientes internados em hospitais, mais especificamente, a espécie bacteriana denominada Klebsiella pneumoniae

-
-
- ENGLISH | PORTUGUÊS
- Trabalhe conosco
- Contato
- Acesso Exclusivo
- Acessibilidade
-
CAMPUS RIBEIRÃO|CAMPUS GUARUJÁ



















